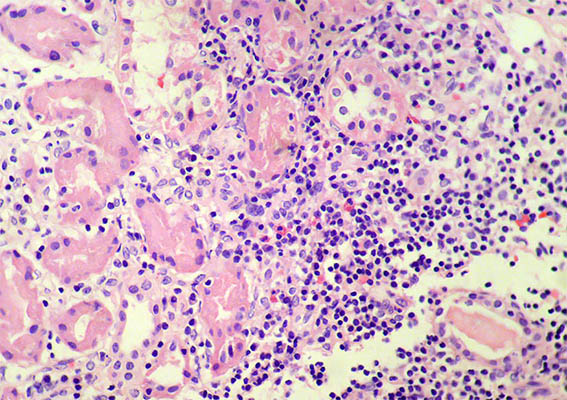

|
|
CASO
199 (septiembre de 2022)
Datos clínicos:
Mujer de 41 años con síntomas secos en mucosa oral y conjuntivas, de aproximadamente 1 año de evolución, manejada empiricamente con humectación oral y "gotas" oftálmicas automedicadas. Evaluada por medicina interna se corrobora la resequedad bucal y oftálmica y se ordenan paraclínicos. Hemoleucograma normal. VSG: 30 mm/h. Creatinina sérica: 1,78 mg/dL, BUN: 28 mg/dL. ANAs: 1:320 moteado fino, anti-Ro: 88,8 UI/mL (normal: <14 UI/mL), anti-La: 34 UI/mL (normal: <14 IU/mL); C3 y C4 normales. ANCAs negativos; Anti-DNA: negativo. Uroanálisis: Proteinas: 150 mg/dL (1,5 g/24 horas), 6-8 eritrocitos/CGA, leucocitos: 5-6/CGA, sin cilindros. Se hace diagnóstico de síndrome de Sjögren y se inicia tratamiento.
Debido a la alteración de la función renal, proteinuria, microhematuria y leucocituria se ordena biopsia renal:

Figura 1. H&E, X100.

Figura 2. H&E, X100. Marcada inflamación tubulointersticial.

Figura 3.
H&E, X400. Hay tubulitis.
Figura 4. H&E, X400. Eosinófilos dispersos.

Figura 5. H&E, X400.

Figura 6. H&E, X400. Glomérulos normales.

Figura 7. Tricrómico de Masson, X200. Áreas con cambios crónicos.

Figura 8. Tricrómico de Masson, X400.

Figura 9. Plata-metenamina, X400. Paredes capilares glomerulares sin alteraciones.

Figura 10. PAS, X200.

Figura 11. ME, aumento original, X2.100. Procesos podocitarios, membranas basales glomerulares y endotelio normales.

Figura 12. ME, aumento original, X2.100. Paredes capilares glomerulares normales.

Figura 13. ME, aumento original, X2.100.
Inmunofluorescencia directa para IgA, IgG, IgM, C3, C1q, kappa y lambda: Negativas.
¿Cuál es su diagnóstico?
Ver
diagnóstico y discusión
[Arriba]
|
|